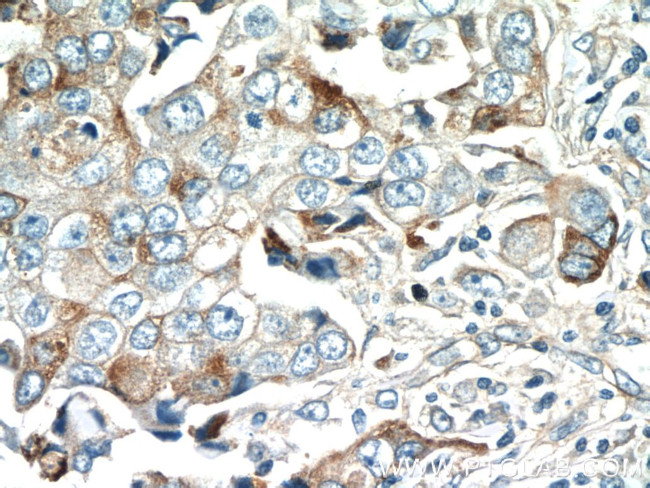
DUSP16 Antibody in Immunohistochemistry (Paraffin) (IHC (P))
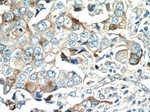
DUSP16 Antibody in Immunohistochemistry (Paraffin) (IHC (P))

Search
Proteintech
DUSP16 Polyclonal Antibody
{{$productOrderCtrl.translations['antibody.pdp.commerceCard.promotion.promotions']}}
{{$productOrderCtrl.translations['antibody.pdp.commerceCard.promotion.viewpromo']}}
{{$productOrderCtrl.translations['antibody.pdp.commerceCard.promotion.promocode']}}: {{promo.promoCode}} {{promo.promoTitle}} {{promo.promoDescription}}. {{$productOrderCtrl.translations['antibody.pdp.commerceCard.promotion.learnmore']}}
产品信息
14237-1-AP
种属反应
宿主/亚型
分类
类型
抗原
偶联物
形式
浓度
规格
纯化类型
保存液
内含物
保存条件
运输条件
产品详细信息
Immunogen sequence: LLHLEKPNE PVPAVSEGGQ KSETPLSPPC ADSATSEAAG QRPVHPASVP SVQPSLLEDS PLVQALSGLH LSADRLEDSN KLKRSFSLDI KSVSYSASMA ASLHGFSSSE DALEYYKPST TLDGTNKLCQ FSPVQELSEQ TPETSPDKEE ASIPKKLQTA RPSDSQSKRL HSVRTSSSGT AQRSLLSPLH RSGSVEDNYH TSFLFGLSTS QQHLTKSAGL GLKGWHSDIL APQTSTPSLT SSWYFATESS HFYSASAIYG GSASYSAYSC SQLPTCGDQV YSVRRRQKPS DRADSRRSWH EESPFEKQFK RRSCQMEFGE SIMSENRSRE ELGKVGSQSS FSGSMEIIEV S (313-662 aa encoded by BC042101)
靶标信息
Dual-specificity phosphatases constitute a large heterogeneous subgroup of the type I cysteine-based protein-tyrosine phosphatase superfamily. DUSPs are characterized by their ability to dephosphorylate both tyrosine and serine/threonine residues. DUSP16 belongs to a class of DUSPs, designated MKPs, that dephosphorylate MAPK proteins ERK, JNK, and p38 with specificity distinct from that of individual MKP proteins. MKPs contain a highly conserved C-terminal catalytic domain and an N-terminal Cdc25-like domain. MAPK activation cascades mediate various physiologic processes, including cellular proliferation, apoptosis, differentiation, and stress responses.
仅用于科研。不用于诊断过程。未经明确授权不得转售。
生物信息学
蛋白别名: Dual specificity protein phosphatase 16; MAP kinase phosphatase 7; MAP kinase phosphatase-7; map kinase phosphatase-M; MAPK phosphatase-7; MGC129701; MGC129702; Mitogen-activated protein kinase phosphatase 7; unnamed protein product
基因别名: 3830417M17Rik; AW558566; D6Ertd213e; DUSP16; KIAA1700; MKP-7; MKP7; Mkpm
UniProt ID: (Human) Q9BY84
Entrez Gene ID: (Human) 80824, (Mouse) 70686, (Rat) 297682